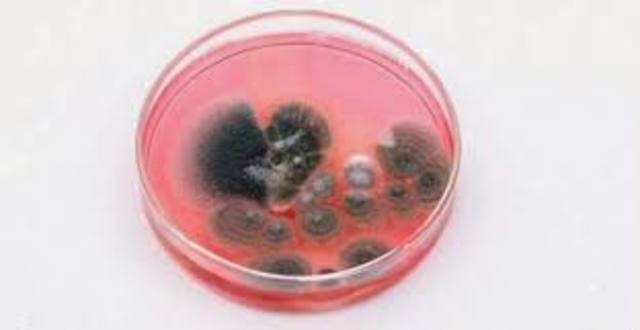
La formacion del hongo

-
El imperio de alejandria se disgrego
-
Bolos de Mendes fue el primer practicante de la khemia greco-egipcia
-
El arte de la khemia entro en declive
-
Zosimo escribió una enciclopedia en 28 volumenes
-
Museo y biblioteca de alejandria sufren grandes daños
-
Los nestorianos llevaron consigo a persia el pensamiento griego
-
Árabes invadieron egipto
-
situaron constatinopla
-
La alquimia árabe rindió sus mejores frutos por el alquimista musulman Jabir
-
Se publico el libro mas valioso sobre metalurgia y quimica aplicada
-
origen a los aspectos médicos de la alquimia
-
Primera cruzada
-
Cristianos europeos conquistaron jerusalen
-
Traducción de una obra árabe de alquimia al latín
-
Principal traductor fue gerardo de cremona
-
Escolasticos europeos pudieron asimilar los hallazgos alquimistas del pasado
-
restos del imperio Bizantino, se extinguian a todas luces
-
Un comtemporaneo de Alberto Magno fue el monje ingles Roger Bacon
-
La alquimia se encuentra en trabajos atribuidos a los españoles
-
Los griegos recuperan la ciudad
-
Primer alquimista europeo Alberto de Bollstadt
-
Gebeer fue el primero en describir el acido sulfurico
-
El papa juan XXIII declaro anatema
-
un inventor aleman proyecto la primera imprecta practica
-
Primer simbolo del progreso tecnologico
-
Los turcos pusieron una cerca sin tregua a la ciudad
-
Nicolás Copérnico mantenia que la tierra no era el centro del universo
-
Perdían flogisto pero el metal enmohecido era mas pesado que el original
-
Espectaculares viajes de cristobal colon
-
Se exploro la costa de africa
-
Andreas vesalius trazo la anatomia humana con una exactitud sin precedentes
-
Se publicaron dos libros revolucionarios
-
Se publico el libro agricola De Re Metalica
-
Galileo Galilei estudio el comportamiento de los cuerpos durante su caida
-
El alquimista aleman andreas libau publico "Una alquimia"
-
El termino alquimia se aplica a todo el desarrollo de la quimica
-
William gilbert demostro que no es solo el ambar el que se comporta asi, sino que otras sustancias adquieren poder de atraccion al frotarlas
-
El aleman Johann Tholde publico un texto mas especializado
-
se publico por primera vez la ley boyle
-
Evangelista Torricelli logro probar que el cile ejercía presión
-
Guericke preparo dos semi esferas de metal
-
Johann Rudolf descubrio un metodo para preparar acido clorhidrico
-
Joham Joachim trato de racionalizar sadiciendo un nuevo nombre
-
Boyle descubrió un nuevo elemento,fósforo a portil de orina
-
Isaac Newton introdujo sus tres leyes de movimiento
-
Química en Europa es prácticamente vacia
-
Thomas Savery construyo una maquina de vapor atmosférica
-
Se establecio la minalogia como ciencia
-
George Brant estudio un mineral azulado que parecia mena de cobre
-
Charles francois descubrio que habian dos tipos de cargas electricas
-
Georg Ernst propuso un nombre nuevo llamado flogisto
-
Hermann boerhaave la combustión ordinaria y el enmohecimiento no podía ser diferentes
-
Benjamin franklin sugirio en la existencia de un solo fluido electrico mayor que la normal
-
Joseph Black mereció la graduación en medicina
-
Calentó fuertemente la piedra caliza
-
Joseph Priestley se hizo cargo de la parroquia en Leeds, Inglaterra
-
Stephen Hales dio un paso en la dirección correcta al recoger gases sobre el agua
-
Cavendish fue el primero en investigar dicho gas que recibió el nombre de hidrogeno
-
lavoisier se interesa en la combustion
-
Epoca en la que se conocian tres gases distintos
-
se aferraban a la vieja concepcion griega de los elementos
-
estaba la validez de la teoría del flogisto
-
Se calento un diamante en un recipiente cerrado hasta que desaparecio
-
Uso del mercurio
-
Prietley fue a Paris y descubrio a Lavoisier
-
RutherFord y priestley se llevaron la fama de los descubrimientos
-
Cavendish estaba trabajando con su gas inflamable
-
Gadolin había descubierto un nuevo óxido metálico (o tierra) en un mineral obtenido de la cantera de Ytterby, cerca de Estocolmo, Suecia.
-
La antigua tradición sostenía que esta sustancia activadora de la transmutación era un polvo seco, Europa fue llamada vulgarmente la piedra filosofal
-
Dalton expuso su version de la teoria atomica
-
Berzelius se lanzon a determinar la constitucion elemental exacta de distintos compuestos
-
Humphry Davy hizo pasar una corriente depotasa fundida y libero pequeños fracmentos de un metal el cual llamo potasio
-
Gay-Lussac dio a conocer la ley de los volumenes de combinacion
-
Amadeo Avogadro " igual número de partículas ocupan volúmenes iguales"
-
william prout sugirio que todos los elementos estaban en definitiva compuesto de hidroseno
-
Pierre Dulong y Alexis Therese descubrieron el calor especifico de los elementos
-
Eilhardt mitscherlich descubrio que los compuestos de composicion semejante tienden a criztalizar juntos
-
Rutherford un ratón en volumen cerrado de aire hasta que murio
-
el inventor inglés John Walker, la primera cerilla de fósforo práctica. Aunque después de un siglo y medio ha experimentado muchas mejoras, el principio sigue siendo el mismo
-
publican primera tabla de pesos atomicos de berzelius
-
Thomas Graham logro demostar que la velocidad de un gas era inversamente proporcional a la raiz cuaddrada de su peso molecular (ley de graham)
-
había sustituido cloro en el lugar ocupado por tres átomos de hidrógeno en el ácido acético
-
Uno de los componentes de la cordita es la
nitroglicerina, descubierta en por el químico italiano Ascanio Sobrero -
su teoría murió y la de Laurent ganó popularidad
-
había estudiado un grupo de compuestos relacionados con el amoniaco y que recibieron el nombre de aminas. Demostró que pertenecían a un tipo con un núcleo de nitrógeno. En el amoniaco, un átomo de nitrógeno estaba unido a tres átomos de hidrógeno
-
estaban ampliando drásticamente los límites aceptados de su ciencia
-
La fuente básica de luz que usaban era el mechero Bunsen
-
demostró que la familia de compuestos orgánicos llamada éteres podía también formarse según el «tipo agua».
-
propuso lo que después llegaría a conocerse como teoría de la valencia.
-
hein-rich Geissler ideo un método para producir vacíos más altos que los que se habían obtenido hasta entonces. Preparo recipientes de vidrio haciendo el vacío en ellos.
-
Gracias al químico francés Henry Etien
ne Sainte-Claire Deville cuando se elaboró un método adecuado para preparar aluminio más o menos puro en cantidades moderadas -
había tratado la anilina con dicromato potásico y estaba a punto de desechar la mezcla resultante como si fuera un nuevo fracaso, cuando sus ojos percibieron un reflejo púrpura en ella. Añadió alcohol, que disolvió algo del preparado y adquirió un hermoso color púrpura
-
procedió en 1858 a elaborar sobre esta base la estructura de las moléculas orgánicas más simples, así como la de los radicales
-
un inventor americano(Edwin Laurentine Drake). Fue el primero
en perforar en busca de petróleo -
Jean servais determino los pesos atomicos como mas exactitud que Berzelius
-
examinaron un mineral con líneas espectrales desconocidas y empezaron a estudiarlo por si se trataba de un nuevo elemento que lo llamaron Cesio
-
Descubrimiento del Rubidio
-
regreso a alemania y alli se lanzo al nuevo campo de la quimica organuca de sintesis que su joven dicipulo habia inagurado
-
Newlands ordenó los elementos conocidos según sus pesos atómicos crecientes, y observó que esta ordenación también colocaba las propiedades de los elementos en un orden, al menos parcial
-
se duplicaban los tintes en el laboratorio
-
un dicipulo de Baeyer, Carl graebe sintetizo la alizarina, otro importante colorante natural
-
John Wesley Hyatt había formado lo que llamó celuloide, y ganó el premio. El celuloide fue el primer plástico sintético
-
Dimitri Ivanovich Mendeleiev había descubierto también el cambio en la longitud de los períodos de los elementos
-
William Crookes ideo un tubo con un vacío más perfecto “el tubo de Crookes” que permitia estudiar con más facilidad el paso de la corriente eléctrica a través del vacío.
-
Se descubrió el Cinc
-
llamo al flujo “rayos catódicos”
-
El botánico alemán Wilhelm Pfeffer demostró en que se podía
medir esta presión osmótica, y a partir de las medidas determinar el peso molecular de las grandes moléculas en la solución coloidal. Fue el primer método razonablemente bueno para estimar el tamaño de dichas moléculas -
Fue descubierto Escandio
-
descubrimiento del escandio
-
un vasto compendio de compuestos orgánicos y utilizó la teoría de los tipos de Laurent para organizar dichos compuestos dentro de un orden racional
-
Hadfield patentó su acero al manganeso
momento que marca el comienzo del triunfo del
acero de aleación. -
El inventor americano George Eastman. En sustituyó el vidrio plano por la película de celuloide, lo cual facilitó tanto las cosas, que la fotografía, hasta entonces privilegio de los especialistas, se pudo convertir en un hobby al alcance de
cualquiera. -
Goldestein realizo algunos experimentos con un cátodo perforado en un tubo en el que había hecho el vacío
-
En 1886, sin embargo, el joven estudiante de químic
a americano Charles Martin Hall , oyendo a su profesor decir que quien descubriese un medio barato de fabricar aluminio se haría rico y famoso, decidió emprender la tarea. -
El químico francés Ferdinand Frédéric Henri
Moissan pasar una corriente eléctrica a través de una solución de fluoruro potásico en ácido fluorhídrico, en su equipo de platino, y consiguió su propósito. Al fin se había aislado el flúor, un gas amarillo pálido. -
Henrich Rudolf Hertz descubrió las ondas de radio dándole posibilidad a la ocurrencia de que la carga positiva se creara quitándole uno o dos electrones del átomo.
-
Moissan le pareció que había triunfado. Obtuvo vari
os diamantes minúsculos e impuros junto con un pedazo de diamante auténtico, de medio milímetro de longitud
aproximadamente. Sin embargo, es posible que Moissa
n fuese víctima de un engaño, y que algún ayudante introdujese el diamante en el hierro. -
Wilhelm Konrad Róntgen Trabajando con un tubo observó un destello de luz que no provenía de éste. A bastante distancia del tubo se hallaba una hoja de papel cubierta con un producto químico que resplandecía.
-
envolvió una película fotográfica en un papel negro y la colocó a la luz del sol, con un cristal de cierto compuesto de uranio encima. El cristal era una sustancia fluorescente; y si la luz emitida fuese simplemente luz ordinaria, no pasaría a través del papel negro ni afectaría a la película fotográfica.
-
descubrimiento del Polonio.
-
descubrimiento del Actinio
-
El químico inglés Frederick Stanley Kipping empezó a investigar en 1899 sobre los compuestos orgánicos que contenía
n el elemento silicio, que, junto con el oxígeno, es el elemento más común en la corteza terrestre. -
descubrimiento del Radon
-
moses gomberg obtuvo una solución coloreada de un compuesto muy reactivo
-
Leonard demostró que el efecto fotoeléctrico se producía por la emisión de electrones por parte del metal.
-
Richard Abegg había señalado que los gases nobles debían poseer una configuración electrónica especialmente estable.
-
Rutherford Estudiando la velocidad de desintegración radiactiva, demostró que, al cabo de un cierto período, diferente para cada elemento, se ha desintegrado la mitad de cualquier cantidad dada de un cierto elemento radiactivo
-
El físico americano Percy William Bridgman en idear un equipo capaz de conseguir presiones cada vez más altas.
-
bombardeando delgadas láminas de metal, con partículas alfa rápidas. La mayoría de las partículas alfa pasaban limpiamente a su través sin ser afectadas ni desviadas, quedando registradas en una placa fotográfica colocada detrás
-
Emil Fischer Demostró que la porción amino de un aminoácido se unía a la porción ácido de otro para formar un enlace peptí-dico
y lo probó -
S. S. Thomson nombro a los rayos producidos por un experimento rayos positivos, que se diferenciaban de los electrones por algo mas que la carga
-
border sugirió que el contenido en plomo de los minerales de uranio podía servir como guía a este respecto
-
fue sintetizado un nuevo compuesto, que se sumó al gran número de productos sintéticos que se conocían pero que carecían de usos determinados.
-
El químico alemán Fritz Haber consiguió su propósito, sometiendo nitrógeno e hidrógeno a altas presiones y utilizando hierro como catalizador
-
el bacteriologo aleman Paul Ehrlich, utilizo la sustancia quimica
-
Baekeland anunció la existencia de lo que él llamó bakelita, el primero y todavía, en cierto modo, uno de los más útiles entre plásticos totalmente sintéticos.
-
El químico alemán Alfred Stock comenzó a estudiar los hidruros de boro (compuestos de boro e hidrógeno) y halló que podían formarse compuestos extraordinariamente complicados, análogos en algunos sentidos a los hidrocarburos
-
quedo definitivamente probado que las partículas de rayos catódicos eran mucho menores que cualquier átomo, esto lo probo el físico Robert Andrews Millikan
-
glover barkla decubrio que cuando los rayos X son desviados por determinados elementos, producen haces que penetran la materia en cantidades características.
-
Thompson había sometido iones de neón cargados positivamente a la acción de un campo magnético.
-
mejoró más tarde el mecanismo y confirmó los resultados, que eran semejantes para otros elementos.
-
el quimico austriaco fritz plegl habia rebelado una eficaz tecnica de micro analisis
-
Moseley halló que su longitud de onda disminuía lentamente a medida que aumentaba el peso atómico de los elementos que los emitían.
-
Rutherford Sugirió que la partícula más Pequeña de los rayos positivos la que tenía la masa del átomo de hidrógeno.
-
Irving langmuir sugirieron una explicación para la estructura de la molécula del cloro, en la que dos átomos de cloro están estrechamente unidos entre sí. Ciertamente, no existe ninguna razón para que un átomo de cloro transfiera un electrón a otro átomo de cloro, y desde luego no podrían mantenerse juntos por atracción electrostática ordinaria.
-
el metalúrgico japonés Kotaro Honda (1870-1954) vio qu
e añadiendo cobalto al acero al tungsteno se producía una aleación capaz de formar un imán más potente que el acero
ordinario. -
se descubrió el protactino.
-
descubrimiento del protactinio
-
El inventor americano Elwoord Haynes
patentó el acero inoxidable, que contenía cromo y níquel. -
Rutherford demostró que las partículas alfa podían arrancar protones de los núcleos de nitrógeno, y fusionarse con lo que quedaba.
-
Rutherford sugirió que su partícula positiva fundamental se denominase protón.
-
logró ampliar en los años veinte el concepto de covalencia por pares electrónicos a los compuestos inorgánicos
-
crookes descubrió que los compuestos de uranio puro recién preparados eran sólo débilmente radiactivos, pero que su radiactividad se reforzaba con el tiempo
-
descubrimiento del Hafnio
-
Broglie aportó razones teóricas para considerar que los electrones poseían propiedades de características de una onda
-
johannes bronsted Dio un nuevo punto de vista acerca de los ácidos y las bases
-
George Eastmanse introdujo la película de acetato de celulosa, en un momento en que la pujante industria del cine necesitaba un material que redujese el riesgo de incendio.
-
el ingles Robert robinson descubrio la estructura de la morfina
-
descubrimiento del elemento Renio
-
El ayudante de Svedberg, Arne Wilhelm Kaurin Tiselius también sueco, ideó métodos mejores para separar las moléculas gigantes en base a las distribuciones de carga eléctrica sobre la superficie molecular. Esta técnica, la electroforesis, tuvo particular importancia en la separación y purificación de proteínas
-
Se descubrio por accidente por el qumico escoses alexander fleming
-
El físico inglés John Douglas Cockcroft y su colaborador, el físico irlandés Ernest Thomas Sinton Walton ( fueron los primeros en diseñar un acelerador capaz de producir partículas lo bastante energéticas como para llevar a cabo una reacción nuclear
-
logró demostrar que el oxígeno estaba formado de tres isótopos.
-
el químico americano Thomas Mid-gley, Jr preparó el freón con una molécula que consistía en un átomo de carbono al que estaban unidos dos átomos de cloro y dos átomos de flúor.
-
el físico americano Ernest Orlando Lawrence diseñó un acelerador que obligaba a las partículas a moverse según una espiral que se ampliaba lentamente. Un ciclotrón relativamente pequeño de este tipo podía producir partículas energéticas.
-
Urey evaporó lentamente cuatro litros de hidrógeno líquido; en el supuesto de que si existía algún isótopo de hidrógeno más pesado, tendría un punto de ebullición más alto, y evaporaría más lentamente, con lo que se acumularía en el residuo
-
A travez de investigaciones del quimico Gerhard domagk se descubrio la sulfanilamida y otros compuestos que se
sumó al gran número de productos sintéticos que se
conocían pero que carecían de usos determinados. -
Químico belga-americano Julius Arthur
Nieuwland en union con el químico americano Wall
ace Hume Carothers había investigado los polímeros relacionados con el caucho, y que tenían algunas de las propiedades elásticas de éste.El resultado, en el año 1932, fue el neopreno, uno de los cauchos sintético o, como se llaman ahora, elastómeros. -
james chandwick descubrió una particula que tenia exactamente la misma masa que el proton, pero no tenia ni una carga eléctrica y se le denomino neutrón
-
pauling sugirio que los atomos de gas noble podían no ser tan resistentes a la formación de enlaces
-
El anti-electrón fue detectado efectivamente por el físico americano Cari David Anderson
-
Dempster halló, por ejemplo, que el uranio, tal como se presentaba en la naturaleza, era una mezcla de dos isótopos, a pesar de que su peso atómico (238,07) se aproximaba a un número entero
-
No sólo se formaron isótopos artificiales, sino tam
bién elementos artificiales. Lawrence, el inventor del ciclotrón, había bombardeado una muestra de molibdeno (número atómico 42) con deuterones (núcleos de hidrógeno-2) enviando la muestra bombardeada a Segré, a Roma. (Más adelante Segré volvería a los Estados Unidos, y en su nueva residencia descubriría el anti-protón). -
Hahn comenzó a preguntarse si no sería
un isótopo radiactivo del propio bario el que se había formado a partir del uranio en el curso del bombardeo neutrónico. Ese bario radiactivo se fusionaría con el bario ordinario, y los dos compuestos no podrían separarse después mediante las técnicas químicas ordinarias. No obstante, tal combinación parecía imposible -
posteriormente se llenaron los tres huecos restantes de la tabla periódica. En 1939 y 1940 se descubrieron los elementos número 87 (francio) y número 85 (as-tato), y en 1947 se rellenó el último hueco, el correspondiente al elemento número 61 (promecio). Todos estos elementos son radiactivos.
-
Posteriormente se llenaron los tres huecos restante
s de la tabla periódic. En 1939 y 1940 se descubrieron los eleme
ntos número 87 francio) y número 85 (as-tato), y en 1947 se rellenó el último hueco, el correspondiente al elemento número 61 (promecio). Todos estos elementos son radiactivos. -
, en 1940, el físico americano Edwin Mattison McMillan y su colaborador el químico Philip Hauge Abelson , en su trabajo sobre el bombardeo neutrónico del uranio, detectaron de hecho un nuevo tipo de átomo.
-
el físico americano Glenn Theodore Seaborg y juntos formaron e identificaron el plutonio, elemento número 94
-
El plutonio, elemento creado por el hombre, se comprobó que también era fisionable, y tras su descubrimiento hubo que esforzarse en producirlo en grandes cantidades.
-
una pila atómica de uranio, óxido de uranio y grafito alcanzó el tamaño «crítico». La reacción en cadena se mantenía, produciendo energía a través de la fisión de uranio.
-
William Doering sintetizo la quinina. Es éste el compuesto cuya búsqueda a ciegas por Perkin había dado resultados tan magníficos
-
en los años veinte Will-státter (véase y Richard Kuhn estudiante de química germano-austriaco,reintrodujeron la técnica. Ésta fue perfeccionada por los químicos ingleses Archer John Porter Martin y Richard Laurence Mi-llington quienes utilizaron papel de filtro absorbente en lugar de la columna de polvo. La mezcla sedeslizaba a lo largo del papel de filtro y se separaba; esta técnica se denomina cromatografía en papel.
-
Un proceso de cultivos de hongos y concentracion de pronductos, rendian media tonelada de penicilina al mes
-
Robert Robinson descubrio la estructura de la estricnina
-
El químico americano Linus Pauling sugirió que la cadena polipeptídica estaba arrollada en una estructura helicoidal (como una «escalera en espiral), que se mantenía en su sitio mediante enlaces de hidrógeno.
-
Woodward paso a sintetizar moleculas organicas mas complicadas como el colesterol ycortisona
-
El químico inglés Frederick Sanger aunque tardó ocho años de trabajo en resolver semejante rompecabezas, en obtuvo el orden exacto de los aminoácidos en la molécula de insulina.
-
Cada molécula de ácido nucleico tenía que poseer una doble
hélice, dos cadenas enrolladas alrededor de un eje común. Este modelo de Watson-Crick, constituyó un importante avance en la comprensión de la genética -
El químico alemán Karl Ziegler descubrió que utilizando
cierta resina (un polímero vegetal natural) podía u
nir a ella átomos de aluminio, titanio
o litio como catalizadores. -
R.B. Woodward sintetizo la estricnina
-
El químico americano Vincent du Vigneaud rompió el hielo sintetizando oxitocina, una pequeña molécula proteica
compuesta de ocho aminoácidos solamente. Pronto lle
garon hazañas más complicadas, y se sintetizaron cadenas de docenas de aminoácidos -
utilizando las técnicas de Brigman, se produjeron
verdaderos diamantes sintéticos -
Utilizando aceleradores gigantes, el físico italo-americano Emilio Segré y su colaborador el físico americano
Owen Chamberlain (lograron producir y detectar el anti-protón) -
woordward sintetizo la re-serpina el primer tranqulizante
-
los quimicos aprendieron a interrumpir la formacion del hongo en su fase media,obtener el nucleo central de la molecula de penicilina
-
Woordward sintetizo la clorofila
-
Max Ferdinand Perutz En el caso de ordenaciones complejas, como las que existen en las moléculas proteicas de
cierta magnitud, la tarea es terriblemente tediosa, pero en 1960 se localizó el último detalle de la molécula de
mioglobina (compuesta de doce centenares de átomos) -
woordward sintetizo un compuesto relacionado con la acromicina un antibiotico muy conocido
-
Vincent du Vigneaud se logró reconstruir en el
laboratorio las cadenas de aminoácidos de la propia
insulina. -
George Johastone Stoney había sugerido u nombre para la unidad fundamental de electricidad, fuese o no partícula. sugirió el nombre de electrón.